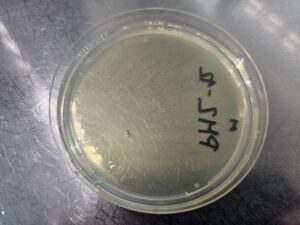
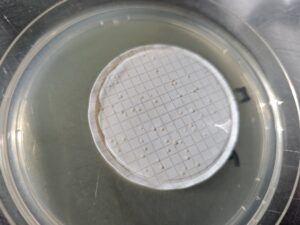

Crtice iz kontrole kvalitete injekcijskih lijekova
Ne treba naglašavati zašto je važno ispitivanje sterilnosti, odsutnosti mikroorganizama u injekcijskim lijekovima. Bilo koji zalutali patogeni mikroorganizam (onaj koji ima sposobnost izazivanja bolesti) mogao bi biti opasan.
Ispitivanje sterilnosti je i statistička kategorija. Kroz nekoliko dana vodim dvoje divnih studenata iz Portugala koji su na zadnjoj godini studija farmacije došli u Hrvatsku učiti svoju struku. Dao sam im zadatak.
Dao sam da ispitaju je li jedan proizvod sterilan. Postoji jednostavan način – na Petrijevu pločicu s hranjivim medijem (agarom) dodali su jedan mililitra otopine. To se naziva direktna inokulacija. Na podlozi nije ništa naraslo i naizgled to bi bilo sterilno. Pitao sam ih – koliko su sigurni u to?
Naime, mi smo uzeli samo jedan mililitar. Što ako bakterija ima malo, manje od jedne bakterije na mililitar? Na podlogu ne može izliti “kantu” proizvoda – čak i mililitar je puno i treba sačekati da se upije u podlogu. Potom smo napravili rutinski trik.
Uzeli smo posebno dizajniranu posudicu u koju stane stotinu mililitara otopine koju smo ispitivali. Na dnu posudice se nalazi filter s vrlo sitnim porama, veličine samo 0,2 mikrometra. To je daleko manje od veličine bakterija i gljivica. Pomoću vakuma svih stotinu mililitara smo pustili da prođe kroz filter, a filter je zadržao sve bakterije. Sliči na ribolov mrežom – mreža je manja od riba. Potom smo filter stavili na hranjivu podlogu.
U roku jednog dana izrasle su 58 kolonije bakterija. To znači da je u stotinu mililitara bilo ih 58, ali u to je manje od jedne bakterije na mililitar. Baš onaj mililitar koji smo uzeli, logično i statistički točno, nije ih sadržavao.
Na ovaj način povećavamo sigurnost testa, kako bismo bili sigurni da nam ne promakne niti jedna potencijalno opasna bakterija ili gljivica.
Ovakvi postupci kontrole jedan su od razloga zašto danas ne trebamo koristiti konzervanse u cjepivima. Drugi razlog je veća tehnološka razina proizvodnje.
Na podlozi na koju smo stavili jedan mililitar otopine nije došlo do porasta bakterija. Kružić koji vidite na ravnoj ploči je mjehurić zraka – oprostit ćemo studentima koji su tek prvi put to radili. Naizgled, ovo je sterilna otopina.
Kad smo tu istu otopinu filtrirali kroz filter od 0,2 mikrometra i koji zadržava na sebi sve bakterije, kad smo ga stavili na hranjivu podlogu na njemu je narastao poveći broj kolonija koje jasno vidite. Tako smo povećali osjetljivost, a time i sigurnost ispitivanja lijekova – čak i mali broj mikroorganizama “uhvatimo” na ovaj način.

